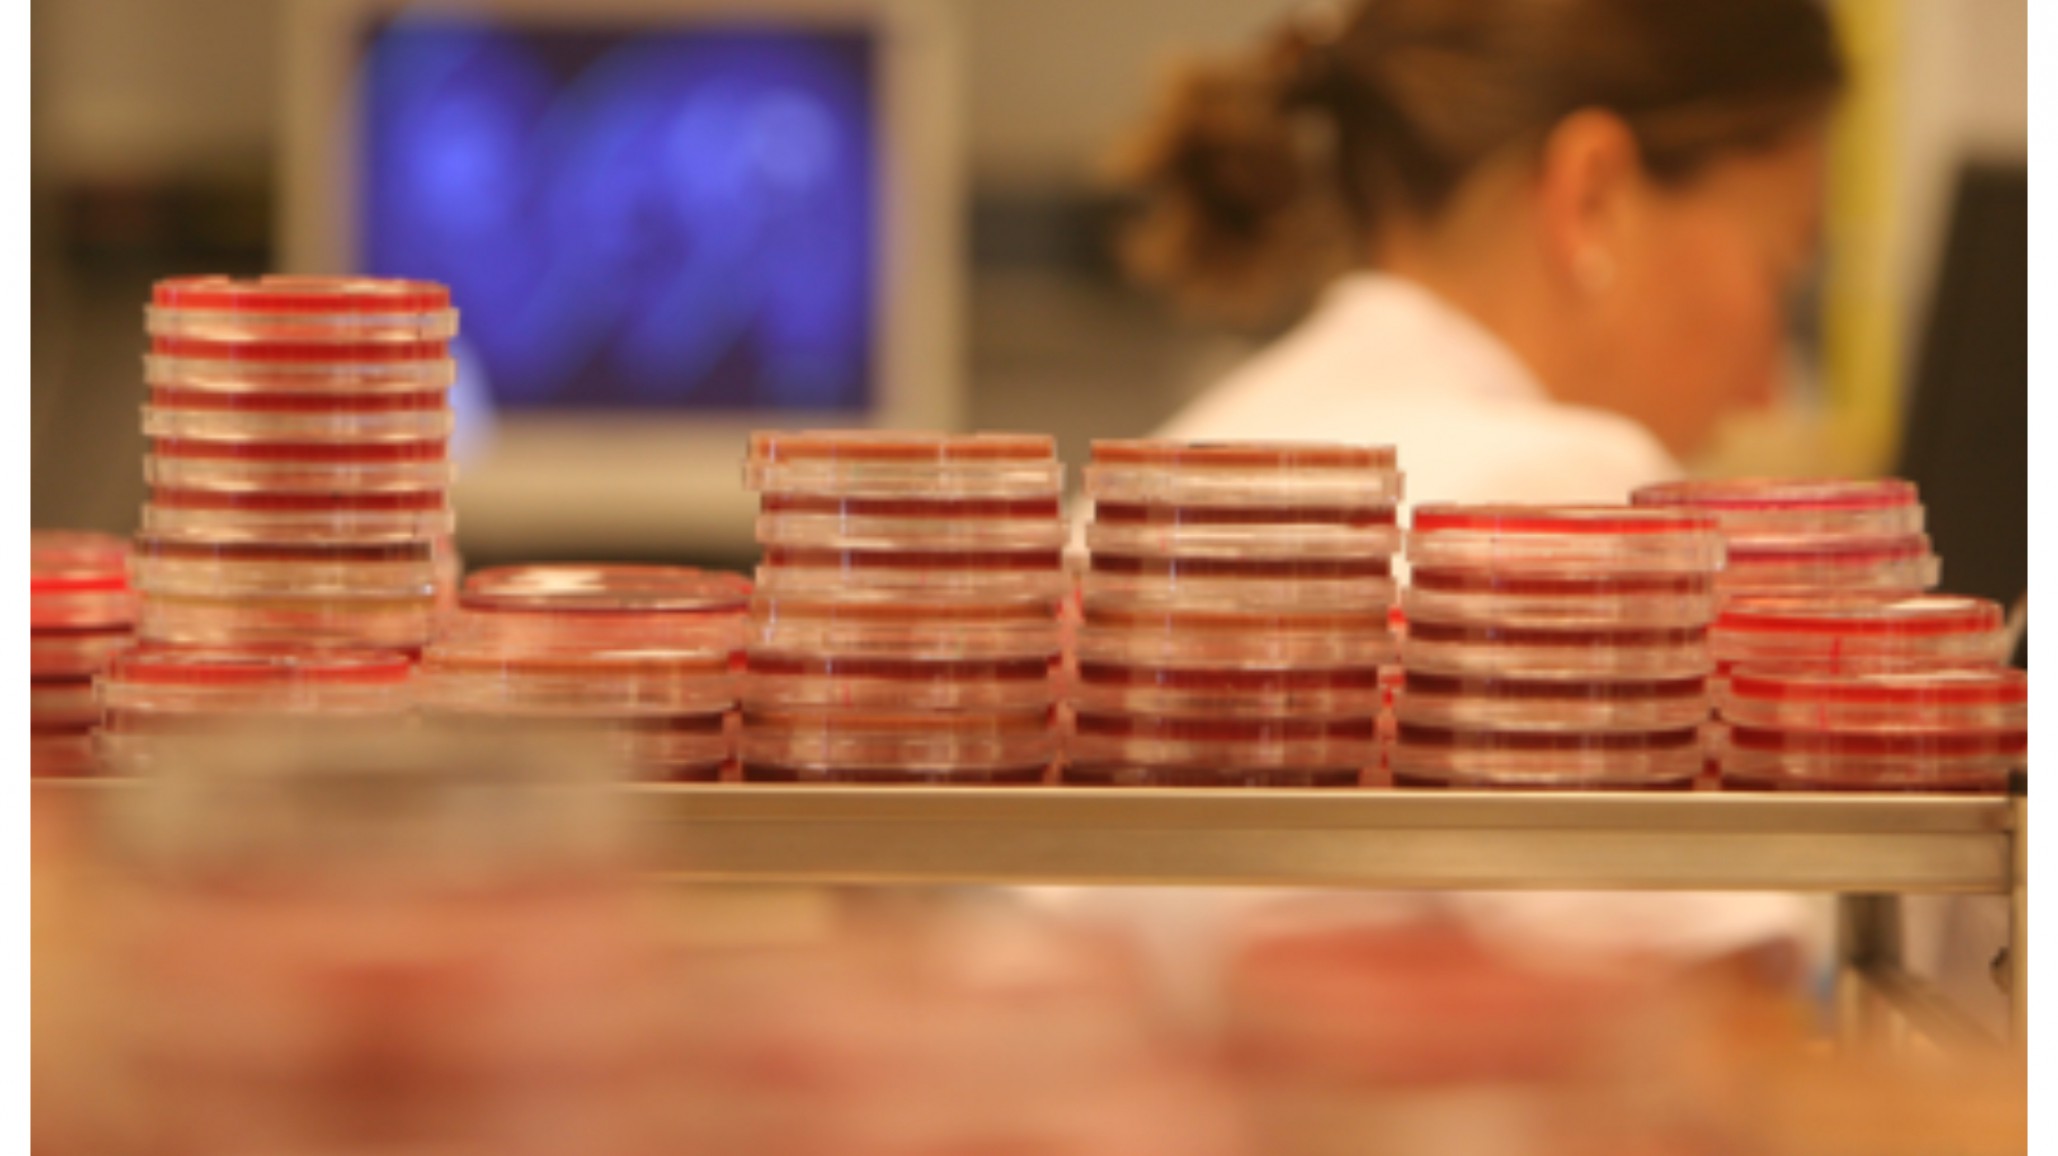
China: la fuga de una bacteria de un laboratorio enfermó a más de 3 mil personas

China: la fuga de una bacteria de un laboratorio enfermó a más de 3 mil personas
El laboratorio dedicado a la producción de vacunas no podrá producir más vacunas tras el grave incidente.
El incidente se registró a mediados del 2019 en un laboratorio de la ciudad de Lanzhou, en la provincia de Gansu, al noroeste de China.
Las autoridades explicaron que el laboratorio estatal estaba a cargo de la realización de la producción de vacunas para animales, cuando sucedió el incidente.
Según informaron autoridades sanitarias, dentro del laboratorio se usó un desinfectante vencido en la producción de vacunas contra la brucelosis para los animales. Por lo que la esterilización fue incompleta y las bacterias quedaron presentes en las emisiones de gas de la planta.
El gas contaminado se propagó por el aire hasta el cercano Instituto de Investigación Veterinaria, donde infectó a casi 200 personas en diciembre pasado. Las personas infectadas a la fecha ascienden a las 3 mil personas.

El virus escapó de un laboratorio de vacunas. Foto: ilustrativa
La brucelosis es una enfermedad transmitida por el ganado o los productos animales, que generalmente no es contagiosa entre los humanos pero puede provocar fiebres, dolor en las articulaciones y de cabeza.
El gobierno chino le revocó la licencia para producir vacunas contra la brucelosis. Los enfermos recibirán una compensación económica a partir de octubre, según las autoridades de Lanzhou.